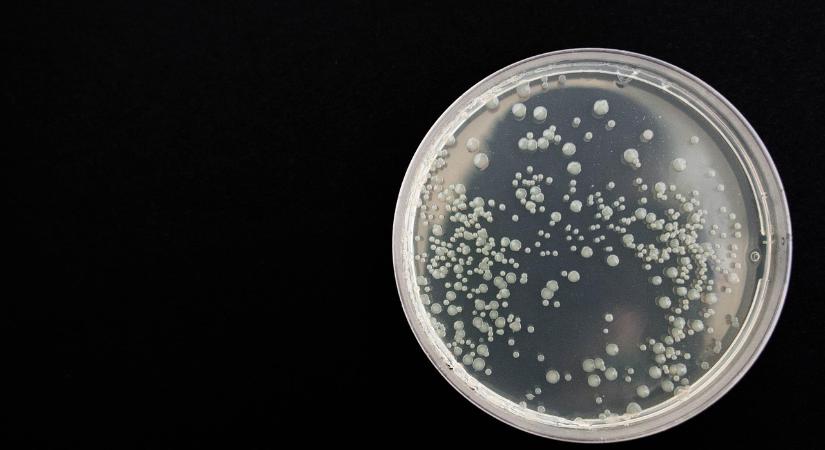
104 éve hunyt el a Petri-csésze megalkotója

104 éve hunyt el a Petri-csésze megalkotója
104 éve hunyt el Julius Richard Petri német bakteriológus, a Petri-csésze megalkotója. Julius Richard Petri (1852–1921) német mikrobiológus volt, akinek nevéhez a róla elnevezett Petri-csésze feltalálása fűződik. Orvosi tanulmányait Berlinben végezte, majd katonai orvosként dolgozott, később pedig a birodalmi egészségügyi hivatalban Robert Koch munkatársa lett. Koch laboratóriumában, az agaralapú baktériumtenyésztés fejlesztése során alkotta meg a […] A 104 éve hunyt el a Petri-csésze megalkotója bejegyzés először Agrotrend-én jelent meg.
- Hirdetés -